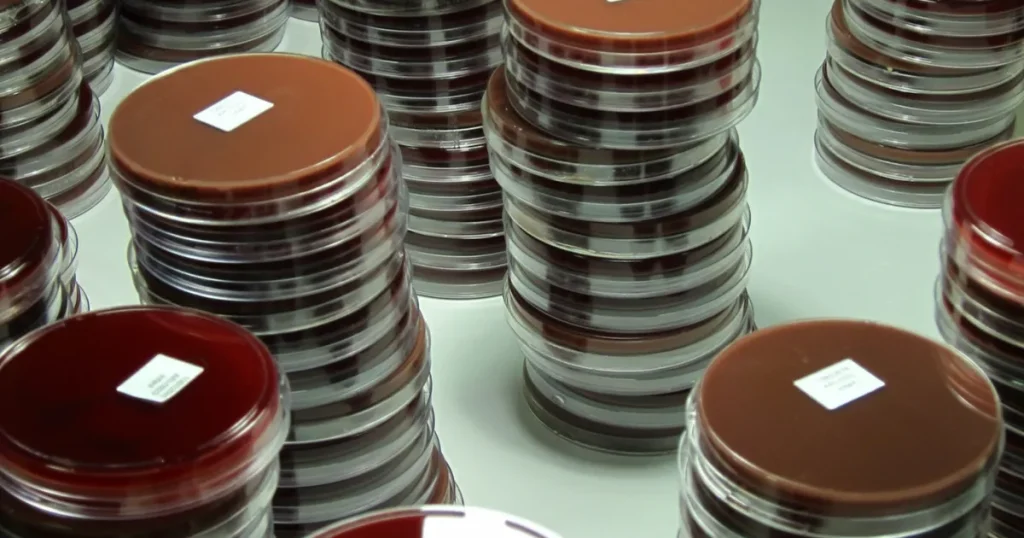
اكتشاف جديد يفتح الباب لحماية الأطفال من الأمراض البكتيرية

توصل باحثون إلى إمكانية تطوير لقاح جديد يمكن أن يفتح الباب أمام حماية الأطفال من عدد كبير من الأمراض البكتيرية التي تتسبب في إصابة نحو 200 مليون طفل حول العالم سنوياً.
واعتبر الباحثون أن هذا الاكتشاف ربما يكون الخطوة الأولى نحو تطوير لقاح يستهدف البكتيريا المعروفة باسم “المستدمية النزلية” وهي بكتيريا تسبب التهابات مختلفة لدى الأطفال، رغم أن اسمها يوحي خطأ بأنها مسؤولة عن الإنفلونزا، مؤكدين أن الدراسة تمثل خطوة مهمة نحو تحديد مزيد من الأهداف المحتملة لتصميم لقاح شامل.
وتظهر البكتيريا “المستدمية النزلية” قدراً مدهشاً من التشابه الجيني، وهو ما يعني أن تطوير لقاح عالمي يمكن أن يكون ممكناً، لأن السلالات تتشارك في خصائص جينية يمكن استهدافها.
وهذا هو التحليل الأول من نوعه الذي يجمع بيانات وراثية جديدة وقديمة للبكتيريا من عينات جرى جمعها من مختلف أنحاء العالم طوال أكثر من 60 عاماً خلال الفترة بين عامي 1962 و2023.
وكشفت النتائج التي نشرتها دورية Nature Microbiology عن مستويات مرتفعة من مقاومة المضادات الحيوية لدى سلالات البكتيريا، إذ تبين أن بعضها أصبح مقاوماً لمعظم فئات المضادات المعروفة.
وشدد الباحثون على أن هذه النتائج تفرض ضرورة ملحة لتعزيز أنظمة المراقبة العالمية الخاصة بهذه البكتيريا، لتتبع تطورها ومراقبة انتشارها الجغرافي.
وذكرت الدراسة أن هناك بالفعل لقاحاً فعالاً جداً ضد سلالة “المستدمية النزلية” من النوع (ب)، وهي السلالة التي تصيب الأطفال بالتهاب السحايا وأمراض أخرى قاتلة، إلا أنه لا يوفر حماية ضد السلالات الأخرى من نفس النوع، ومن بينها سلالة المستدمية النزلية غير النمطية، التي تعد السبب الرئيسي لالتهاب الأذن الحاد لدى الأطفال، وتسبب نحو 175 مليون حالة سنوياً على مستوى العالم، كما تتسبب أيضاً في التهابات الجيوب الأنفية والعينين، وغالباً ما تكون سبباً في الالتهاب الرئوي الذي يعد من أخطر الأمراض، خصوصاً في الدول محدودة الموارد.
وأجرى العلماء أول دراسة شاملة لتسلسل الجينوم الكامل للبكتيريا على نطاق عالمي، استخدموا فيها تقنيات علم الجينوم المقارن لتحليل انتشارها وتطورها في المجتمعات الأكثر عرضة للإصابة، مثل سكان المناطق الحدودية بين تايلندا وميانمار.
قام الفريق بجمع عينات من مسحات أنفية لأطفال يعيشون في مخيم ماييلا للنازحين في تايلندا، وتمكنوا من معرفة تسلسل 4474 جينوماً للبكتيريا، ثم دمجوا هذه النتائج مع 5976 جينوماً منشوراً سابقاً لتشكيل خريطة عالمية لتطور وانتشار المستدمية النزلية.
وأظهرت النتائج أن أكثر من 95% من حالات الالتهاب الرئوي في المخيم كانت ناجمة عن سلالة المستدمية النزلية غير النمطية، ما يدل على قدرتها العالية على إحداث المرض وتفوقها على السلالات الأخرى.
وأشار الباحثون إلى أنهم لم يجدوا أي طفرات جينية معينة تجعل بعض السلالات أكثر قدرة على التسبب في الالتهاب الرئوي من غيرها، ما يعني أن جميعها تملك الإمكانات نفسها لإحداث المرض.
وكشفت الدراسة عن انتشار واسع لمقاومة متعددة للأدوية بين عينات تلك السلالة في تايلندا وفي مناطق أخرى حول العالم. ومن خلال تحليل واسع للبيانات الجينومية العالمية، وجد الفريق أن “المستدمية النزلية” لا تظهر أنماطاً تطورية خاصة بكل بلد أو منطقة، على عكس العديد من البكتيريا الأخرى المسببة لأمراض الجهاز التنفسي، مثل المكورات الرئوية أو المكورات السحائية.
وأفادت بأن البكتيريا، رغم ارتفاع معدلات إعادة التركيب الجيني بينها – أي تبادل المواد الوراثية بين السلالات المختلفة أثناء التكاثر – إلا أن التباين الجيني الإجمالي فيها يظل منخفضاً، وأوضح الباحثون أن هذا الأمر يعتبر مثالاً واضحاً على ما يعرف بـ “الانتقاء السلبي المستمر”، وهو ما يعد خبراً جيداً بالنسبة لتطوير اللقاحات، لأن هذا الثبات الجيني يعني وجود مناطق مستقرة يمكن استهدافها باللقاحات.
وقال المؤلف المشارك في الدراسة، نيل ماكالاسدير، الباحث في المعهد الأوروبي للمعلومات الحيوية، إن تسلسل الجينوم على نطاق واسع مكّن العلماء من رؤية أنماط تطور وانتشار الأمراض المعدية على مستوى السكان، وهو ما لم يكن ممكناً سابقاً.
وأكد أن تحليل قرابة 10 آلاف عينة من “المستدمية” النزلية أتاح تأسيس قاعدة معرفية متينة لفهم تنوعها الجيني مقارنة بالسلالة الوحيدة التي يوجد لها لقاح حاليا.
وأضاف ماكالاسدير، أن البكتيريا رغم ميلها الشديد لإعادة تركيب جيناتها، إلا أن هناك آليات تطورية تحفظ معظم أجزاء الجينوم من التغيير، وأن فهم هذه المناطق الثابتة ربما يكون المفتاح لتطوير لقاح فعال يمنع جميع أشكال العدوى التي تسببها هذه البكتيريا، ما يقلل من الاعتماد على المضادات الحيوية واسعة الطيف التي يفقد الكثير منها فعاليته.
وقالت المؤلفة المشاركة في الدراسة “آنا بونتينن” الباحثة بجامعة أوسلو في النرويج، إن نتائج الدراسة كشفت أن البكتيريا المسببة للأمراض التنفسية، وعلى خلاف كثير من الأنواع الأخرى، لا توجد لها تجمعات محلية أو إقليمية منفصلة جينياً.
واعتبرت أن هذا الاكتشاف مشجع للغاية، لأن وجود سلالات محلية مختلفة كان سيجعل تطوير لقاح عالمي أكثر صعوبة، موضحة أن الدراسة تدعم الفرضية الأصلية التي انطلق منها الباحثون وهي أنه يمكن بالفعل تطوير لقاح شامل يحمي من جميع أنواع العدوى التي تسببها “المستدمية النزلية”.